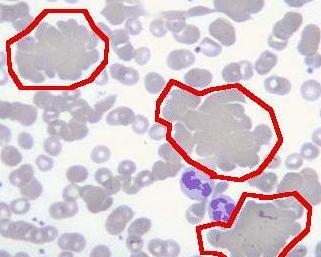
急性白血病是正细胞贫血吗 0

急性白血病是正细胞贫血吗
∪▽∪ *** 次数:1999998 已用完,请联系开发者***
急性白血病是正细胞贫血吗严重吗
警惕骨髓纤维化,四项检测揭示是否向急性白血病转变!贫血、肝脾肿大等症状。随着病情进展,还可能出现血小板和白细胞减少的情况。该病可分为原发性和继发性两种类型:前者由基因突变引起;后者则多由其他类型的骨髓增生性疾病转化而来,如血小板增多症、真性红细胞增多症等。 值得注意的是,骨髓纤维化确实存在转化为急性白血病的...
急性白血病是正细胞贫血吗能治好吗

急性白血病是正细胞贫血吗怎么治疗
为何白血病儿童逐年增多?医生告诫:多半与3个因素有关,需警惕白血病是一类造血系统的恶性肿瘤性疾病,分为急性白血病和慢性白血病。 一旦患病,患者会出现非常明显且严重的贫血现象,还会伴有高烧以及异常出血等症状。如果没能及早治疗,会使患者在短时间内快速死亡,对患者的生命有着较大危害。 白血病好发于13岁以下的儿童当中,而且近些...
急性白血病属于什么贫血
急性白血病所致贫血属于哪种类型的贫血
?▂? “白血病”专挑孩子下手,建议:这3种食物,孩子再馋也不要买她接到医院的电话——原来刚刚入院的小芳出现了不明原因的贫血和反复发热症状。经过详细检查,医生告知家长,小芳被确诊为急性白血病。... 可能在微妙中激活某些潜在的细胞突变风险,从而埋下隐患。第三类需要警惕的是高温煎炸食品。煎炸过程中,高温会产生丙烯酰胺等有害物质...
急性白血病是血液病吗

急性白血病以什么细胞为主
现在越来越多孩子患“白血病”,常见的4类水果,或含大量甲醛近年来,儿童白血病发病率呈上升趋势,这一现象引发了医学界与社会的广泛关注。某三甲医院血液科曾接诊过一名5岁患儿,因长期食用反季节水果出现反复发热、贫血症状,最终确诊为急性淋巴细胞白血病。医生在排查病因时发现,孩子家中常备的“催熟香蕉”“染色橙子”等水果,竟成...
急性白血病贫血主要原因是

白血病到最后,都是怎么死的?医生叹气:多半是因三个致命因素患有急性髓系白血病(AML)的他,经过了几轮化疗,却仍然抵挡不住病情的反复发作。因反复低热、贫血与感染等状况,整个人瘦骨嶙峋。目睹病情... 患者体内健康白细胞的数量急剧减少,抑或丧失正常功能,从而难以抵御病原微生物的侵袭。一旦感染来袭(如肺炎、败血症等),身体就难以发动有...

+▽+ 港股概念追踪|北京扩大造血干细胞移植医保报销范围 干细胞相关医药...北京市医保局近日发布通知,扩大造血干细胞移植医保报销范围。本市医保参保人如果符合12类适应证,进行造血干细胞移植的费用纳入医保报销。12类适应证包括:急性白血病;慢性白血病;淋巴瘤;多发性骨髓瘤;骨髓增生异常综合征;再生障碍性贫血;嗜血细胞综合征/噬血细胞综合征;阵发...
![]()
迅达加速器部分文章、数据、图片来自互联网,一切版权均归源网站或源作者所有。
如果侵犯了你的权益请来信告知删除。邮箱:xxxxxxx@qq.com
上一篇:天行加速器电脑版官网
下一篇:oppo手机ins详细教程